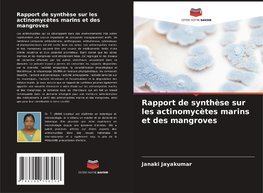
Rapport de synthèse sur les actinomycètes marins et des mangroves

-
 Francúzsky jazyk
Francúzsky jazyk
Rapport de synthèse sur les actinomycètes marins et des mangroves
Autor: Janaki Jayakumar
Na objednávku
33.30 €
bežná cena: 37.00 €
O knihe
- Vydavateľstvo: Editions Notre Savoir
- Rok vydania: 2025
- Formát: Paperback
- Rozmer: 220 x 150 mm
- Jazyk: Francúzsky jazyk
- ISBN: 9786208756208

 Anglický jazyk
Anglický jazyk 










